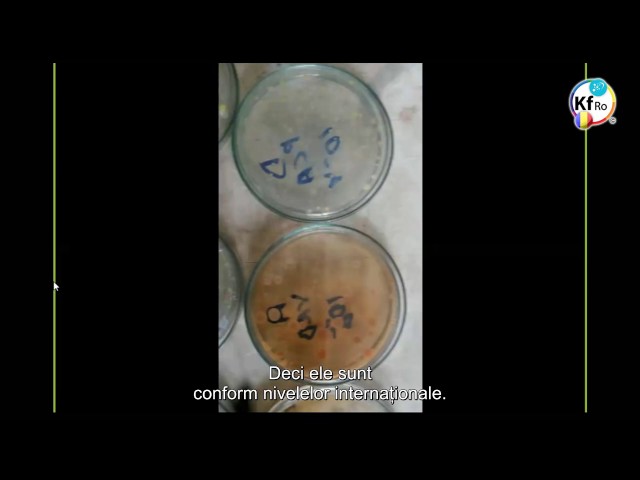
Curatarea Apei de Bacteria Ecoli

BUN VENIT!
Pagina Asociației Keshe România se află în proces de reconstrucție. Vă mulțumim pentru înțelegere și suport.
Pentru a ne contacta, vă rugăm să ne scrieți la: contact@kesheromania.ro
CUNOAȘTERE PLASMATICĂ
DECONTAMINARE
SĂNĂTATE
TRANSPORT
ENERGIE